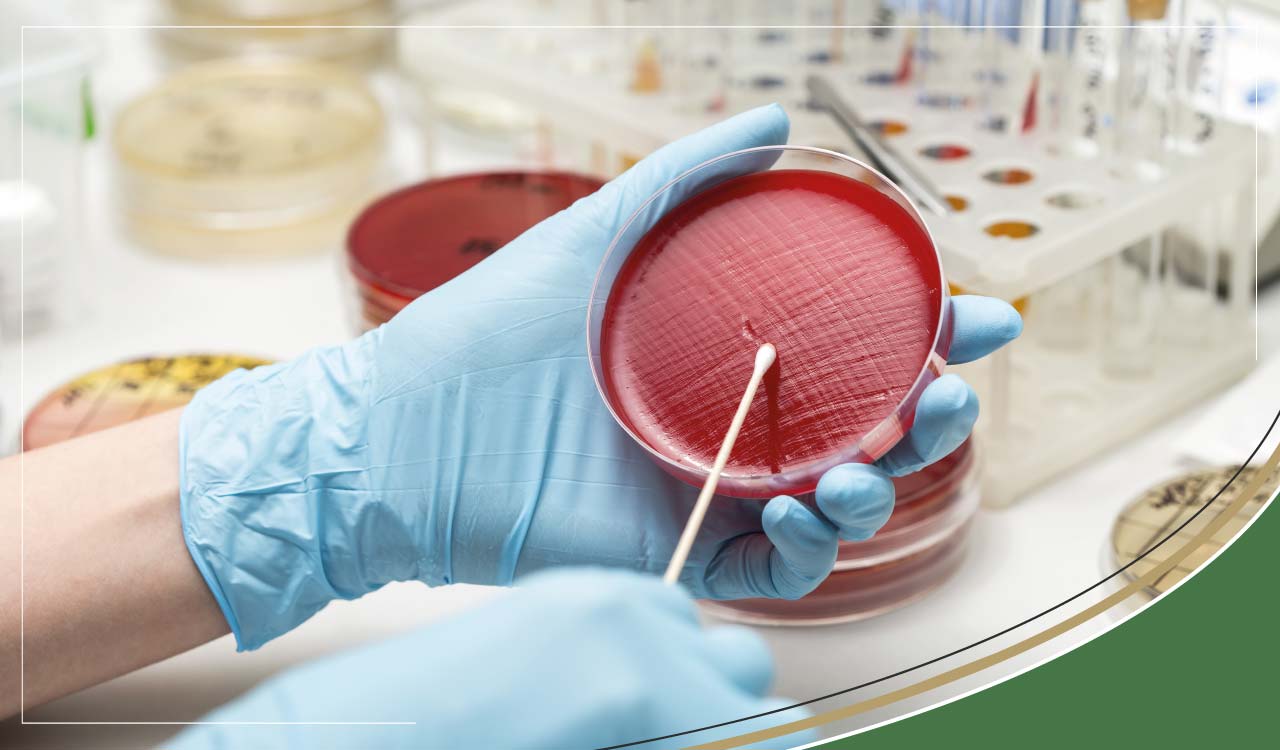

Urine Culture Test | Finding the Cause of UTI
A urine culture test is used to detect microorganisms such as fungi or bacteria that may be causing a urinary tract infection (UTI). Bacteria can quickly get into the urethra from the skin surrounding the urethral opening. These germs can spread to the bladder and, if left untreated, can continue to the ureters and kidneys causing more severe damage.
But a bacterium does not just enter from without but can also remain dormant within cells for years. Hultgren (1998) was the first to discover that bacteria, traditionally regarded as extracellular, can behave in an intracellular way to invade bladder cells in a survival process that means bacteria form supportive communities known as biofilms. Bacteria, protected in biofilms in infected cells, are more resistant to antibiotic treatments.
These biofilm bacteria are up to 1000-fold more tolerant and resistant to antibiotics than previously. When conditions are right for growth, “the bacteria begin detaching from the biofilm and leave the cell to re-initiate an acute infection in the urinary tract.” (Gregory G. Anderson, Hultgren’s Lab). (Hoiby et al. 2010). In fact, after as much as a month of antibiotic exposure, it is estimated that a possible 10 million of the original 1 billion bacteria may remain in the urinary tract.
Should you be asked to give a sample of your urine to send away for culturing because you are experiencing symptoms of a urinary tract infection or if urinalysis has shown raised numbers of white blood cells indicating an infection, here are some tips for collecting a clean-catch midstream sample of urine:
- Use your first urine of the day since bacteria levels will be higher and therefore more readily detected.
- Wash your hands before collecting a sample
- Clean around the genital area thoroughly.
- After a few seconds of urinating, collect approximately 60ml of urine in a sterile container being careful not to contaminate the sample by touching the rim with the genital area.
- Replace the sample lid and wash your hands.
- Take your sample to be sent off. If it needs to be kept for more than an hour, it can be refrigerated for up to 24 hours.
Collecting a urine sample with a catheter
To obtain a sample from a catheter, cleanse the port (at the end of the tubing near to the collection bag) with an alcohol swab. Then, with a sterile syringe, obtain a sample from the catheter tubing and transfer to a sterile collection tub and replace the lid.
What happens once the urine sample is sent off for culture testing?
The sample is stored in conditions that promote the growth of bacteria/fungus. The test will show up as negative if very few or no organisms grow. The culture is positive if there are significant numbers of organisms to cause an infection. A count of 100,000 or more bacteria per millilitre indicates an infection, between 100 and 100,000 could either be caused by infection or the sample being contaminated (so you may have to give another sample for repeat testing), 100 or less may be seen if antibiotics have been commenced. If you are taking diuretics, this may also alter the culture test since the bacteria in the urine will be diluted. Also, the culture test may be more accurate in identifying the bacteria in more established infections (rather than at the beginning of one).
Sensitivity Test
The sensitivity test investigates the specific treatments that will be most effective against the bacteria/fungus that has been found in the culture test. Many bacteria are now antibiotic resistant due to our overuse of antibiotics in medicine and farming. In addition to the problem of overuse, antibiotics are frequently misused with people not taking them at the right dose or at the right times or not completing the course which leads to the weaker bacteria being killed off while the stronger being able to evolve and thrive developing resistance next time the antibiotic is used. A culture test may be repeated as a follow up after treatment to check whether the infection has cleared.
The difference between a Urine Culture Test and Urinalysis
Urinalysis (UA) looks at the chemistry of the urine and can be used to indicate a urinary problem or UTI but cannot detect the number or the type of bacteria present.
A Urine culture and sensitivity test can tell you exactly what bacteria are present and the numbers involved in an infection. Once the bacteria type has been established, it can help identify the best possible approach whether that's by antibiotics, dietary control, supplements or all three.
 Free Shipping on orders $100+ SGD
Free Shipping on orders $100+ SGD
 Worldwide Delivery Available
Worldwide Delivery Available
 Read Thousands of Independent Reviews
Read Thousands of Independent Reviews


















